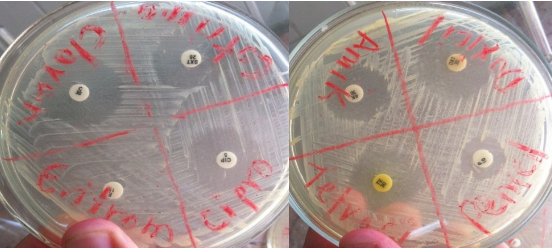
Halos de inhibicin del Staphylococcus aureus producidos por siete de los antibiticos utilizados en la investigacin

NOTAS DE INVESTIGACIÓN
Comparación de actividad in vitro anti-Staphylococcus aureus de ocho antibióticos y cuatro diluciones de propóleos
Comparison of in vitro anti-Staphylococcus aureus activity of eight antibiotics and four dilutions of propolis
Comparación de actividad in vitro anti-Staphylococcus aureus de ocho antibióticos y cuatro diluciones de propóleos
Journal of the Selva Andina Research Society, vol. 13, núm. 1, pp. 35-48, 2022
Selva Andina Research Society
Recepción: 01 Abril 2021
Corregido: 01 Julio 2021
Aprobación: 01 Diciembre 2021
Publicación: 01 Febrero 2022
Resumen: El objetivo de esta investigación se basó en la comparación de halos de inhibición de una muestra de Staphylococcus aureus, enfrentada in vitro a ocho antibióticos de uso en medicina, así como, al enfrentamiento a cuatro concentraciones alcohólicas de propóleos. Los resultados señalan que la acción antimicrobiana de propóleos, depende de los compuestos bioactivos como: flavonoides, polifenoles, ácidos aromáticos, etc., contenidos en este producto. La actividad antibacteriana de las cuatro diluciones de propóleos, produjeron halos de inhibición entre 10 y 20 mm. De los ocho antibióticos con los que se realizó la comparación, solo la eritromicina resultó ser resistente a S. aureus. La penicilina produjo los halos con menores dimensiones. Aunque los halos derivados por el resto de los antimicrobianos fueron mayores a los del propóleos, muchos de ellos se encontraron dentro del rango originado por dicho producto de la colmena, no se ha demostrado resistencia antibacteriana comparada, con la que a lo largo de los años los antibióticos presentan, al ser usados indiscriminadamente para eliminar o controlar agentes antimicrobianos.
Palabras clave: Propóleos, extracto etanólico, antimicrobiano, halos, inhibición.
Abstract: The objective of this research was based on the comparison of inhibition halos of a sample of Staphylococcus aureus, faced in vitro with eight antibiotics used in medicine, as well as four alcoholic concentrations of propolis. The results indicate that the antimicrobial action of propolis, depending on the bioactive compounds such as: flavonoids, polyphenols, aromatic acids, etc., contained in this product. The antibacterial activity of the four propolis dilutions produced inhibition halos between 10 and 20 mm. Of the eight antibiotics with which the comparison was made, only erythromycin was found to be resistant to S. aureus. Penicillin produced halos with smaller dimensions. Although the halos derived from the rest of the antimicrobials were greater than those from propolis, many of them were found within the range originated by said product from the hive. Compared antibacterial resistance has not been demonstrated, with which over the year’s antibiotics present, when used indiscriminately to eliminate or control antimicrobial agents
Keywords: Propolis, ethanolic extract, antimicrobial, halos, inhibition.
Introducción
Los antibióticos constituyen al tratamiento de enfermedades infecciosas. El desarrollo de mecanismos evolutivos, por parte de los microorganismos para evadir la acción antibiótica, genera riesgos en la terapia y la salud, animal como humana. A pesar de los avances en la investigación, búsqueda y desarrollo de nuevos antimicrobianos, frecuentemente se reportan situaciones difíciles, al tratar infecciones bacterianas que, por su uso indiscriminado presentan, resistencia a estos1.
Durante los últimos años diversos microorganismos han desarrollado resistencia a diferentes drogas utilizadas para su control. Dentro de estos, se destaca la alta resistencia que presentan Escherichia coli y Staphylococcus aureus a los antibióticos, constituyéndose las principales causas de enfermedades intrahospitalarias2. S. aureus presenta resistencia a la meticilina entre un 50 a 85 % de los aislados en todo el mundo3.
Los estafilococos son microorganismos aerobios Gram-positivos. El más patogénico de ellos, S. aureus, típicamente es causante de infecciones de la piel, a veces neumonía, endocarditis y osteomielitis, en general se lo asocia con la formación de abscesos. Algunas cepas elaboran toxinas que causan gastroenteritis, síndrome de la piel escaldada y síndrome de shock tóxico. El diagnóstico se realiza con tinción de Gram y cultivo, en su tratamiento suele incluirse beta-lactámicos resistentes a las penicilinasas, pero como es frecuente la resistencia a antibióticos puede ser necesario el uso de vancomicina u otros fármacos más modernos4.
Debido a la alta resistencia de los patógenos en México frente a los diversos tratamientos con antibióticos sintéticos como: ampicilina, ciprofloxacino, ceftriaxona (los que han demostrado susceptibilidad por debajo del 60 %), se buscan tratamientos de origen natural y amigables para el medio ambiente5.
El propóleo es un producto natural e inocuo empleado en la medicina tradicional desde tiempos ancestrales, por sus propiedades biológicas, una sustancia de composición compleja y aspecto resinoso, elaborado por abejas Apis melífera L. a partir de la vegetación adyacente a la colmena, estos insectos colectan los exudados de las plantas, tejidos dañados como medida de protección, resinas, lacas, gomas y aceites6.
La actividad biológica de los propóleos se debe a su composición química a base de: 55 % de resinas y bálsamos, 30-40 % de cera de abeja, 5-10 % de aceites esenciales o volátiles, 5 % de polen y de otros materiales orgánicos y minerales7. La fracción resinosa del propóleos está integrada por compuestos fenólicos y flavonoides que son muy importantes a nivel terapéutico8, presentan un efecto sinérgico esencial para las actividades biológicas benéficas en humanos como animales: antibacteriana, antifúngica, antiviral, antioxidante, inmunomoduladora, entre otras9.
Debido a la capacidad antimicrobiana que proporcionan los polifenoles, en mayor parte, flavonoides, esteres y ácidos fenólicos, se atribuyen a los propóleos diferentes efectos benéficos para la salud10.
Entre otros compuestos del propóleos aparte de los polifenoles se encuentran: ácido cafeico, ácido ferúlico, ácido isoferúlico, ácido 3,4-dimetoxicinámico, pinobanksina, éster bencílico del ácido cafeico, éster fenetílico del ácido cafeico, apigenina, pinocembrina, crisina y galangina, etc11. Los flavonoides, ácidos aromáticos, diterpenoides y compuestos fenólicos se consideran como los principales constituyentes químicos responsables de las propiedades biológicas del propóleos12.
La actividad antimicrobiana, una propiedad fundamental de los propóleos, su acción bacteriostática, bactericida está basada en la inhibición de ácidos nucleicos y degradación de la membrana citoplasmática, principalmente se le atribuye a los flavonoides como pinocembrina, quercetina, naringenina, acacetina, apigenina, crisina, galangina, kaempferol y pinobanskina13, así como alteración en los canales iónicos a consecuencia de reacciones de fosforilación y desfosforilación, disminuyendo la inhibición de la motilidad bacteriana.
Akca et al.14 plantean, que los mecanismos antimicrobianos que muestran los flavonoides son: inhibición de la motilidad, inhibición de la síntesis de ácidos nucleicos, inhibición de las funciones de la membrana citoplasmática, inhibición del metabolismo energético, inhibición de la unión y formación de biopelículas, inhibición de las porinas y atenuación de la patogenicidad.
Los flavonoides son compuestos conformados por dos anillos fenilo, A y B, unidos a través de un anillo C de pirano con grupos funcionales adicionales, lo que genera diferentes tipos de flavonoides, como las chalconas, flavanonas, flavonas, flavonoles, proantocianidinas, antocianidinas, flavandioles, isoflavonas y auronas, compuestos que le dan las características antioxidantes, antimicrobianas, cicatrizantes, antiinflamatorias15.
Aparte del papel activo que juegan los flavonoides en la destrucción de los organismos, afectan fuertemente los tejidos conectivos al inhibir algunas de las enzimas que pueden hidrolizar su red de proteoglicanos y proteínas. Esta malla dificulta estéricamente la difusión de organismos infecciosos a través del tejido16.
Dada sus propiedades antimicrobianas, el propóleos es objeto de innumerables estudios donde se evaluó el efecto inhibitorio sobre bacterias como: E. coli, Lactobacillus plantarum, S. aureus, S. epidermidis, Pseudomonas aeruginosa, P. fluorescens, Listeria monocytogenes, L. innocua, Klebsiella pneumoniae, Salmonella typhimurium, S. enteritidis, Streptococcus agalactiae, S. mutans, Bacillus cereus, B. subtilis, Citrobacter freundii, Enterobacter aerogenes, Shigella dysenteriae, Yersinia enterocolitica, Pantoea agglomerans, Vibrio cholerae, entre otras, los resultados son variables aun tratándose del mismo microorganismo12,17.
Ensayos in vitro han demostrado que los extractos de propóleos son más eficaces frente a los cocos Gram (+) (S. aureus, Streptococcus β-haemolyticus) y que solo actúan frente a algunas bacterias Gram (-) como E. coli . P. aeruginosa18.
Autores como Gil et al.19 y Agurto Mendizábal & Cuya López20 obtuvieron actividad antimicrobiana con efecto bacteriostático parcial y bactericida al aplicar extractos etanólicos de propóleos venezolanos, europeos y mexicanos20, contra el S. aureus, al utilizar concentración mínima inhibitoria (CMI) y concentración mínima bactericida (CMB) de 1 % y 2 %, y CMI de 62.5 μg/mL y 125 μg/mL.
Al considerar que el uso excesivo de antibióticos acarrea la resistencia antimicrobiana de las bacterias, y resulta necesario estudiar tratamientos de origen natural contra ellas, el objetivo de este trabajo se basó en realizar una comparación de los halos de inhibición de una muestra de S. aureus luego de aplicar de manera in vitro discos de antibiograma de ocho antibióticos utilizados en salud y discos de cuatro concentraciones etanólicas de propóleos, con el fin de obtener resultados satisfactorios con las soluciones de propóleos y así contar con un producto natural e inocuo para el enfrentamiento del microorganismo analizado.
Materiales y métodos
La cepa de S. aureus que se empleó en esta investigación partió del banco de cepas perteneciente al Centro de Higiene y Epidemiología de la provincia de Sancti Spíritus, Cuba, se aisló de un paciente que presentaba una lesión de piel. En el Laboratorio de Referencia para Investigaciones y Salud Apícola (LARISA), el microorganismo se sembró en medio agar nutriente (AN), después de su incubación y crecimiento a 37 ºC/ 24 h, se conservó en refrigeración, hasta el momento de su uso para el trabajo investigativo, dicha bacteria se confrontó a ocho antibióticos, así como, a cuatro diluciones alcohólicas de propóleos. El propóleos fue adquirido en la Empresa APICUBA, encargada de comercializar este producto de la colmena.
Las diluciones de extractos etanólicos de propóleos (EEP) se prepararon con agua destilada, alcohol y propóleos bruto según el volumen a preparar y cantidad en gramos de dicho producto que se necesitaba para cada dilución. Para realizar las diluciones se tomó en cuenta el método descrito por Sforcin21, quien utilizó 30 g de propóleos para elaborar una dilución en 100 mL de alcohol al 70 %, aunque en las condiciones del laboratorio se partió de una muestra de propóleos (30 g), a la que se le adiciono 100 mL de alcohol al 96 %, de esta formulación pura, se realizaron los distintos cálculos de las diluciones con menor concentración de propóleos y alcohol. Luego de elaborar las cuatro soluciones, estas se mantuvieron en recipientes ámbar resguardados de la luz durante 14 días. Varias veces al día todas las diluciones se homogenizaron para ayudar al propóleos a aportar sus propiedades bioactivas en el preparado etanólico.
Al final del plazo las diluciones fueron depuradas en papel de filtro estéril, manteniéndose los extractos en frascos ámbar a temperatura ambiente.
| EEP | 20% | 15% | 10% | 5% |
| Propóleos (g) | 20 g/100 mL | 15 g/100 mL | 10 g/100 mL | 5 g/100 mL |
| Alcohol | 64º | 48º | 32º | 16º |
| Agua destilada (mL) | 34 | 51 | 67 | 84 |
En la investigación se utilizaron además discos de antibiograma de ocho antibióticos usados en el control de la bacteria nombrada anteriormente, fueron proveídos por el Ministerio de Salud Pública de Cuba, correspondientes a la Marca Liofilchem, Italia con número de Lote: 093019116.
En el trabajo de laboratorio, bajo condiciones de esterilidad dentro de una Cabina de Seguridad Biológica, se utilizaron dieciocho placas Petri estériles con el medio de cultivo AN, en cada una de las placas se realizó la siembra de S. aureus luego de tomarse una azada bien cargada de un cultivo previo. En el medio se estriaron las colonias de bacteria, efectuándose este proceso a todo lo ancho de las placas. Con ayuda de un lápiz cristalográfico se dividieron en cuatro cada placa. En cada sección enmarcada se detalló el antibiótico que se utilizaría para verificar la CMI de S. aureus, por lo que, seis placas contenían los discos de antibiograma de: amikacina, cloranfenicol, tetraciclina y penicilina, y otros seis con los discos de: doxiciclina, ciprofloxacino, cotrimoxazol y eritromicina. En las restantes seis placas se adicionaron discos de papel de filtro previamente esterilizados y embebidos durante 24 h con las diluciones de propóleos 20, 15, 10 y 5 %. Luego, todas las placas se encubaron a 37 ºC/ 24 h, después se midió los halos de inhibición, producidos por los antibióticos como las diluciones etanólicas del propóleos.
Al no contarse en el laboratorio con el medio de cultivo agar Mueller Hilton (ANH), medio ideal para la lectura del antibiograma, se empleó AN, donde también se comprobó el crecimiento e inhibición de S. aureus.
Para realizar el análisis estadístico de los resultados se utilizó Statgraphics Versión 5.1 en español para Windows22, se realizaron las Pruebas de Contraste t de comparación de medias (t-test) para conocer si existían diferencias significativas en los resultados obtenidos para los diferentes porcientos a los que se aplicaron las tinturas del propóleos.
Resultados
| Antibiótico | amikacina | cloranfenicol | tetraciclina | penicilina | doxiciclina | ciprofloxacino | cotrimoxazol | eritromicina |
| 1 | 20 | 16 | 18 | 10 | 19 | 23 | 20 | 0 |
| 2 | 20 | 20 | 17 | 7 | 20 | 21 | 23 | 0 |
| 3 | 16 | 22 | 17 | 12 | 21 | 21 | 20 | 0 |
| 4 | 20 | 24 | 19 | 12 | 24 | 23 | 23 | 0 |
| 5 | 17 | 27 | 19 | 9 | 20 | 23 | 25 | 0 |
| 6 | 16 | 24 | 19 | 3 | 21 | 20 | 11 | 0 |
| Promedio | 18.1666667 | 22.16666667 | 18.16666667 | 10.5 | 20.833333 | 21.83333333 | 20.16666667 |
| EEP (%) | 20 | 15 | 10 | 5 |
| 1 | 15 | 15 | 14 | 11 |
| 2 | 15 | 13 | 12 | 10 |
| 3 | 16 | 16 | 13 | 14 |
| 4 | 15 | 17 | 13 | 14 |
| 5 | 20 | 13 | 12 | 10 |
| 6 | 20 | 15 | 12 | 12 |
| Promedio | 16.8333333 | 14.83333333 | 12.6666667 | 11.8333333 |
De los ocho antibióticos utilizados, se obtuvo actividad antimicrobiana frente a S. aureus con siete de ellos, la eritromicina no mostró inhibición (Tabla 2). Las cuatro diluciones etanólicas de propóleos dieron halos de inhibición contra el microorganismo en mayor o menor medida. Aunque con la mayoría de los antibióticos se alcanzaron halos superiores a los obtenidos con las soluciones de propóleos, sus halos presentaron similitudes a los producidos por los antibióticos, además, al comparar las diluciones de propóleos al 10 y 5 %, obtuvimos halos de inhibición mayores a los reportados por la penicilina (Tabla 3).
Al realizar el análisis estadístico entre los antibióticos se obtuvieron diferencias que beneficiaron principalmente al cloranfenicol, doxiciclina, ciprofloxacino y cotrimoxazol. La amikacina y tetraciclina mostraron diferencias altamente significativas al compararlas con la penicilina.
Las medias obtenidas al promediarse los halos de inhibición de las seis réplicas de antibióticos amikacina y cloranfenicol (Figura 1), amikacina y ciprofloxacino (Figura 2), cotrimoxazol y penicilina (Figura 3), luego de las lecturas al cabo de 24 h de incubación.

Letras diferentes expresan diferencia significativa, beneficiándose el cloranfenicol con un P-Valor = 0.0470679

Letras diferentes expresan diferencia significativa, beneficiándose la ciprofloxacino con un P-Valor = 0.00419613

Letras diferentes expresan diferencia significativa, beneficiándose el cotrimoxazol con un P-Valor= 0.00132035
Como se menciona con anterioridad al comparar los halos producidos por la amikacina y la tetraciclina, con los de la penicilina, se encontraron diferencias altamente significativas con valores de p=0.000105 644 . 0.0000178965, contra el S. aureus.
En la Figura 4 los halos de inhibición frente a S. aureus producto a la acción antimicrobiana de los antibióticos, así como, la ausencia de halos por parte de la eritromicina.
Como se aprecia, la bacteria también es inhibida en medio agar nutriente, en ausencia del medio agar Mueller Hilton.
Durante el análisis estadístico de las cuatro concentraciones etanólicas de propóleos se encontró diferencias entre las diluciones del 20-10, 20-5, 15-10 y 15-5 %, siendo beneficiadas las soluciones del 20 y 15 %. Al comparar las tinturas de propóleos con los antibióticos, se obtuvieron diferencias que favorecieron a la mayoría de los antibióticos. Entre la dilución del 20 % y la amikacina, tetraciclina, cotrimoxazol no se encontraron diferencias estadísticas al contar con resultados similares en cuanto a los halos de inhibición de la bacteria estudiada. Solo se alcanzaron diferencias significativas al confrontar las concentraciones de propóleos del 20 y 15 %, y compararlas con los resultados arrojados por la penicilina (P= 0.000947989. 0.00329998). Aunque las diluciones del 10 y 5 % mostraron halos de inhibición mayores a los producidos por este último antibiótico, no arrojaron diferencias estadísticas.
En las Figuras 5 y 6 los resultados de las medias obtenidas al promediarse los halos de inhibición de las seis réplicas de propóleos al 20 y 10 % (Figura 5), propóleos al 15 y 5 %, (Figura 6) luego de las lecturas al cabo de 24 h de incubación.

Letras diferentes expresan diferencia estadística significativa, beneficiándose la solución del 20 % con un P-Valor= 0.00294017

Letras diferentes expresan diferencia estadística significativa, beneficiándose la solución del 15 % con un P-Valor= 0.012966
Además de estos análisis entre las soluciones etanólicas del propóleos, también se obtuvieron diferencias estadísticas significativas al comparar las tinturas del 20-5 y 15-10 %, viéndose favorecidas en todo momento, las diluciones del 20 y 15 %.
Se puede advertir con claridad la inhibición producida por las cuatro soluciones etanólicas de propóleos, las que podrían haber sido mayores, de mantenerse en incubación por 24 h más, pero se decidió concluir la investigación con un tiempo igual al utilizado con los antibióticos.

Discusión
García Rodríguez et al.23 exponen en un trabajo previo, los patrones estándar del halo de inhibición para S. aureus frente a un gran número de antibióticos, algunos de estos se utilizaron en esta investigación: penicilina (resistente halos ≤ 28 mm, no hay rango para intermedio, mientras que, la bacteria sería sensible halos ≥ 29 mm), eritromicina (resistente halos ≤ 13 mm, intermedio 14-22 y sensible ≥ 23 mm), ciprofloxacino (resistente halos ≤ 15 mm, intermedio 16-20 y sensible ≥ 21 mm), cloranfenicol (resistente halos ≤ 12 mm, intermedio 13-17 y sensible ≥ 18 mm), tetraciclina (resistente halos ≤ 14 mm, intermedio 15-18 y sensible ≥ 19 mm). Al analizar los promedios que alcanzaron algunos de los antibióticos que se utilizaron en este trabajo, luego de compararlos con los patrones estándar del halo de inhibición propuestos por García Rodríguez et al.23, Staphylococcus spp., muestra sensibilidad a ciprofloxacino y cloranfenicol, mientras que, frente a tetraciclina su inhibición recae al rango intermedio.
Según Mensa et al.24 más de 90 % de aislados S. aureus producen betalactamasas que inactivan la penicilina, siendo una de las causas que en dicha investigación la penicilina provocó menor inhibición de S. aureus. Koneman et al.25 plantean, que S. aureus desarrolla resistencia a antibióticos como penicilina y eritromicina, coincidiendo nuestros resultados con lo expuesto por dichos autores.
La actividad antimicrobiana del propóleos se atribuye a sus compuestos: ácidos fenólicos, cumarinas, alcaloides, flavonoides, ésteres, aldehídos fenólicos y cetonas un alto potencial antimicrobiano, acción antibiótica, fungicida, antiviral y antitumoral, entre otras26-28. La presencia de triterpenos pentacíclicos constituye una característica importante de la composición química del propóleos, vinculada a su actividad antiinflamatoria, anticancerígena y antiviral29. Boisard et al.30 en estudios antimicrobianos in vitro con propóleos revelaron que la actividad inhibitoria frente a bacterias Gram-positivas pertenecientes a los géneros Staphylococcus y Streptococcus, está dada por la pinocembrina, un flavonoide presente en dicho producto de la colmena. Según Popova et al.31, las abejas A. melífera elaboran propóleos ricos en diterpenos totarol y totarolona, quienes han mostrado actividad antimicrobiana contra S. aureus. Trusheva et al.32 plantean que la propolina C, D, F y G inhiben el crecimiento de cepas bacterianas Gram-positivas (S. aureus, B. subtilis, L. monocytogenes y Paenibacillus larvae), mostrando la propolina C, la mayor actividad antibacteriana contra la bacteria estudiada, quien fue resistencia a la meticilina, quedando demostrado que los Gram-positivos presenten elevada susceptibilidad a la acción de los principios activos del propóleos, ya que, la pared celular de estas bacterias está formada por un solo tipo de molécula en comparación con las bacterias Gram-negativas, que tienen su pared compuesta por varias capas, y por ende, son más resistentes a la actividad antimicrobiana de dicho producto de la colmena33.
Los resultados alcanzados con las soluciones EEP muestran halos de inhibición mayores y también en menor escala a los obtenidos por Ferreira Bastos et al.34, en su investigación aplicaron contra S. aureus dieciséis muestras de propóleos, alcanzando halos de inhibición entre 8 y 23 mm. Datos semejantes a los de esta investigación fueron reportados por Kujumgiev et al.35, en un estudio de la actividad antimicrobiana del propóleos de diferentes países, obtuvieron halos de inhibición entre 11 y 29 mm para S. aureus. Tovalino & Contreras36, in vitro investigaron el efecto antibacteriano de dos soluciones de propóleos de Oxapampa-Perú (10 y 30 %) contra S. aureus (ATCC 25923), al 30 % mostró mayor inhibición con una media de 11.77 mm. En esta investigación se obtuvieron resultados superiores con las cuatro diluciones utilizadas. Gómez et al.37, utilizaron concentraciones de EEP 20, 40, 60, 80 y 100 % (diluciones en alcohol al 96 %), contra el S. aureus en la que alcanzaron halos entre 13 y 17 mm, determinándose la dilución 20 % como la de mayor CMI. Cabrera-Rojas38, utilizó soluciones etanólicas de propóleos entre 90, 80, 70 y 60 % contra la bacteria estudiada, y obtuvieron halos de inhibición de 28.5 mm, 27.5 mm, 17.1 mm y 8.5 mm. Las diluciones de 90 y 80 % provocaron los mayores halos, y fueron más elevadas que las obtenidas en nuestro trabajo, aunque, con las concentraciones del 70 y 60 % utilizadas por el autor, obtuvieron halos que coinciden con los alcanzados en esta investigación, y también menores, quedando demostrado que, con soluciones más bajas, se logra la inhibición de dicho microorganismo. Bucio-Villalobos & Martínez-Jaime39, obtuvieron halos de inhibición de 1.6 cm con EEP. Gil et al.19 en su investigación mediante la técnica de macro dilución en tubo demostraron que S. aureus puede ser inhibido con EEP en concentraciones muchos más bajas de 2 y 1 %. Agurto Mendizábal & Cuya López20 alcanzaron halos de inhibición de 12 mm al utilizar EEP procedentes de Ayacucho y Huaral (México), contra el S. aureus. Iguales resultados se obtuvieron en este trabajo con diluciones de 10 y 5 %, en las que además se observaron halos de 13 y 14 mm.
Díaz-Mena et al.40, al evaluar la actividad antimicrobiana de EEP cubanos por el método de dilución en agar demostró que los EEP presentaron un efecto marcadamente mayor frente a bacterias Gram-positivas, con valores de CMI entre 0.025 y 10 %, coincidiendo sus resultados con los de nuestra investigación, se obtuvo inhibición del crecimiento de S. aureus, Gram-positiva, con una concentración de 10 %. Otros investigadores como Mercan et al.41 y Gonsales et al.42 encontraron actividad antibacteriana en muestras de propóleos de Turquía, Panamá y Sao Paulo, contra bacterias Gram-positivas, como el S. aureus.
Según Moreno et al.43, durante su investigación con diluciones de propóleos, cuando S. aureus se incuba 48 h, se incrementa su efecto bactericida. En su estudio concluyeron que, el 70 % de las muestras de propóleos incrementó su actividad antimicrobiana luego de un tiempo de incubación de 48 h al compararlo con el efecto detectado a las 24 h. Como en esta investigación las lecturas tanto para los antibióticos como para las diluciones de propóleos se realizaron a las 24 h de incubación, este tiempo pudo influir en que no se obtuvieran halos de inhibición mayores para las concentraciones de propóleos, de haberse mantenido en incubación por dos días.
Al tomar en consideración la investigación de Bucio-Villalobos & Martínez-Jaime39 quienes comprobaron que al utilizar el etanol como un tratamiento de control contra S. aureus dicho reactivo no provocó ningún efecto inhibitorio, en comparación con la inhibición provocada por el EEP, se decidió no aplicarlo como otro tratamiento de control, en este trabajo.
El EEP puede ser una alternativa en tratamientos antibacterianos, pues es un producto natural al cual no se le ha demostrado resistencia y cuya única contraindicación hasta ahora es que el paciente sea alérgico a los productos apícolas44.
De los ocho antibióticos utilizados en la investigación solo la eritromicina no produjo inhibición de S. aureus en comparación con las cuatro diluciones etanólicas del propóleos, se obtuvo inhibición de la bacteria con todas las soluciones. Frente a los patrones con los que se cotejaron los halos de inhibición producidos por los antibióticos, el microorganismo resultó sensible al ciprofloxacino y cloranfenicol, ante la tetraciclina su inhibición recayó en el rango de intermedio. La acción antimicrobiana de la penicilina se vio inactivada por las betalactamasas que produce este microorganismo al entrar en contacto con este antibiótico. Las concentraciones de propóleos 20 y 15 % provocaron los mayores halos de inhibición del microorganismo por parte de este producto de la colmena. Durante el análisis estadístico ambas concentraciones arrojaron diferencias significativas al comparar los halos producido por estas, con los obtenidos con el antibiótico penicilina. Aunque los halos derivados por los EEP del 10 y 5 % fueron mayores a los de la penicilina, no se obtuvo diferencia estadística al compararlos con dicho antibiótico. Todas las soluciones de propóleos arrojaron inhibición del microorganismo analizado y, aunque en este trabajo no se comprobó la presencia de sus compuestos bioactivos como se citaron por algunos autores, se puede estimar por los resultados alcanzados, que el propóleos cubano cuenta con dichas propiedades biológicas.
Literatura Citada
1. Resistencia a los antimicrobianos [Internet]. Organización Mundial de la Salud. 2020 [citado 5 de marzo de 2021]. Recuperado a partir de: http://www.who.int/mediacentre/factsheets/fs194/es/
2. Cabrera CE, Gómez RF, Zúñiga AE. La resistencia de bacterias a antibióticos, antisépticos y de-sinfectantes una manifestación de los mecanismos de supervivencia y adaptación. Colomb Méd 2007;38(2):149-58.
3. Gil de MM. Staphylococcus aureus: Microbiología y aspectos moleculares de la resistencia a meticilina. Rev Chil Infectol 2000;17(2):145-52. DOI: https://doi.org/10.4067/S0716-10182000000200010
4. Portillo ME, del Pozo JL. Infecciones por estafilococo. Medicine 2018;12(49):2890-4. DOI: https://doi.org/10.1016/j.med.2018.02.002
5. Reyes-Acevedo M, Toro V, Chávez G, Lagos-Hernández R, Godoy-Cumillaf A, Caniuqueo-Vargas A. Vigilancia de la resistencia bacteriana en instituciones de salud de la ciudad de Hermosillo, Sonora, México. Salud Pública Méx 2018;60 (2):117-8. DOI: https://doi.org/10.21149/8446
6. Palomino García LR, Martínez Galán JP, García Pajón CM, Gil González JH, Durango Restrepo DL. Caracterización fisicoquímica y actividad antimicrobiana del propóleos en el municipio de la unión (Antioquia, Colombia). Rev Fac Nac Agron Medellín 2010;63(1):5373-83.
7. Sforcin JM, Bankova V. Propolis: is there a potential for the development of new drugs? J Ethnopharmacol 2011;133(2):253-60. DOI: https://doi.org/10.1016/j.jep.2010.10.032
8. Rodríguez Pérez B, Canales Martínez MM, Penieres Carrillo JG, Cruz Sánchez TA. Composición química, propiedades antioxidantes y actividad antimicrobiana de propóleos mexicanos. Acta Univ 2020;30:e2435. DOI: https://doi.org/10.15174.au.2020.2435
9. Soto-Vásquez MR. Metabolitos secundarios, cuantificación de fenoles y flavonoides totales de extractos etanólicos de propóleos de tres localidades del Perú. Crescendo 2015;6(2):22-32.
10. Da Cunha MG, Franchin M, de Carvalho Galvão LC, de Ruiz AL, de Carvalho JE, Ikegaki M, et al. Antimicrobial and antiproliferative activities of stingless bee Melipona scutellaris geopropolis. BMC Complement Altern Med 2013;13:23. DOI: https://doi.org/10.1186/1472-6882-13-23
11. Li A, Xuan H, Sun A, Liu R, Cui J. Preparative separation of polyphenols from water-soluble fraction of Chinese propolis using macroporous absorptive resin coupled with preparative high performance liquid chromatography. J Chromatogr B Biomed Appl 2016;1012-1013:42-9. DOI: https://doi.org/10.1016/j.jchrom.2015.12.038
12. Siripatrawan U, Vitchayakitti W, Sanguandeekul R. Antioxidant and antimicrobial properties of thai propolis extracted using ethanol aqueous solution. Int J Food Sci Technol 2013;48(1):22-7. DOI: https://doi.org/10.1111/j.1365-2621.2012.03152.x
13. Vargas-Sánchez R, Torrescano-Urrutia GR, Mendoza-Wilson AM, Vallejo-Galland B, Acedo-Félix E, Sánchez-Escalante JJ, et al. Mecanismos involucrados en la actividad antioxidante y antibacteriana del propóleos. Biotecnia 2014;16(1):32-7. DOI: https://doi.org/10.18633/bt.v16i1.31
14. Akca AE, Akca G, Topçu FT, Macit E, Pikdöken L, Özgen IS. The comparative evaluation of the antimicrobial effect of propolis with chlorhexidine against oral pathogens: An in vitro study. Biomed Res Int 2016;2016:3627463. DOI: https://doi.org/10.1155/2016/3627463
15. Panche AN, Diwan AD, Chandra SR. Flavonoids: an overview. J Nutr Sci 2016;5:e47. DOI: https://doi.org/10.1017/jns.2016.41
16. Farnesi AP, Aquino-Ferreira R, De Jong D, Bastos JK, Soares AE. Effects of stingless bee and honey bee propolis on four species of bacteria. Genet Mol Res 2009;8(2):635-40. DOI: https://doi.org/10.4238/vol8-2kerr023
17. Osés SM, Pascual-Maté A, Fernández-Muiño MA, López-Díaz TM, Sancho MT. Bioactive properties of honey with propolis. Food chem 2016;196:1215-23. DOI: https://doi.org/10.1016/j.foodchem.2015.10.050
18. Mayta-Tovalino F, Sacsaquispe Contreras S, Ceccarelli Calle J, Alania Mallqui J. Propóleo peruano: Una nueva alternativa terapéutica antimicrobiana en Estomatología. Rev Estomatol Hered 2012;22(1):50-8. DOI: https://doi.org/10.20453/reh.v22i1.159
19. Gil M, Gonzalez M, Orlandi O, Ugas K, Nicita G, Perozo E. Actividad bacteriostática y bactericida de extractos etanólicos de propóleos venezolanos y europeos sobre Escherichia coli y Staphylococcus aureus. MedULA 2018;25(1):6-12.
20. Agurto Mendizábal JC, Cuya López E. Actividad antimicrobiana del extracto etanólico liofilizado de propóleo procedente de Ayacucho y Huaral frente a Staphylococcus aureus y Pseudomonas aeruginosa [tesis licenciatura]. [Lima]: Universidad Nacional Mayor de San Marcos; 2021 [citado 26 de octubre de 2021]. Recuperado a partir de: https://cybertesis.unmsm.edu.pe/handle/20.500.12672/16527
21. Sforcin J. Efeito da sazonalidade sobre as propriedades imunomoduladora e antibacteriana da própolis e perfil bioquímico de ratos [tesis doctoral]. Botucatu: Universidade Estadual Paulista Botucatu; 1996.
22. Statgraphics 19 centurion [Internet]. Statgraphics 19 centurion. 2000 [citado 5 de marzo de 2021]. Recuperado a partir de: https://www.statgraphics.com/
23. García Rodríguez JA, Cantón R, García Sánchez JE, Gómez-Lus MªL, Martínez Martínez L, Rodríguez-Avial C, et al. Métodos básicos para el estudio de la sensibilidad a los antimicrobianos. En: Picazo JJ, editor. Procedimientos en Microbiología Clínica [Internet]. Granada: Sociedad Española de Enfermedades Infecciosas y Microbiología Clínica; 2000. p. 1-54. Recuperado a partir de: https://www.seimc.org/contenidos/documentoscientificos/procedimientosmicrobiologia/seimc-procedimientomicrobiologia11.pdf
24. Mensa J, Soriano A, Llinares P, Barberán J, Montejo M, Salavert M, et al. Guía de tratamiento antimicrobiano de la infección por Staphylococcus aureus. Rev Esp Quimioter 2013;26(Suppl 1): S1-S84.
25. Koneman E, Allen S, Janda W, Schreckenberger P, Winn Jr W. Diagnostico Microbiologico: Ed. Médica Panamericana. 2008:71.
26. Burdock GA. Review of the biological properties and toxicity of bee propolis (propolis). Food Chem Toxicol 1998;36(4):347-63. DOI: https://doi.org/10.1016/s0278-6915(97)00145-2
27. Duke CC, Tran VH, Duke RK, Abu-Mellal A, Plunkett GT, King DI, et al. A sedge plant as the source of Kangaroo Island propolis rich in prenylated p-coumarate ester and stilbenes. Phytochemistry 2017;134:87-97. DOI: https://doi.org/10.1016/j.phytochem.2016.11.005
28. Delgado Aceves MdL, Andrade Ortega JÁ, Ramírez Barragán CA. Caracterización fisicoquímica de propóleos colectados en el Bosque La Primavera Zapopan, Jalisco. Rev Mex Cienc Forestales 2015;6(28):74-87.
29. Ito J, Chang FR, Wang HK, Park YK, Ikegaki M, Kilgore N, et al. Anti-AIDS agents. 48.(1) Anti-HIV activity of moronic acid derivatives and the new melliferone-related triterpenoid isolated from Brazilian propolis. J Nat Prod 2001;64(10):1278-81. DOI: https://doi.org/10.1021/np010211x
30. Boisard S, LeRay A-M, Landreau A, Kempf M, Cassisa V, Flurin C, et al. Antifungal and antibacterial metabolites from a French poplar type propolis. Evid Based Complement Alternat Med 2015;2015:319240. DOI: https://doi.org/10.1155/2015/319240
31. Popova MP, Chinou IB, Marekov IN, Bankova VS. Terpenes with antimicrobial activity from Cretan propolis. Phytochemistry 2009;70(10): 1262-71. DOI: https://doi.org/10.1016/j.phytochem.2009.07.025
32. Trusheva B, Popova M, Koendhori EB, Tsvetkova I, Naydenski C, Bankova V. Indonesian propolis: chemical composition, biological activity and botanical origin. Nat Prod Res 2011;25(6):606-613. DOI: https://doi.org/10.1080/14786419.2010.488235
33. Akca AE, Akca G, Topçu FT, Macit E, Pikdöken L, Özgen IS. The Comparative evaluation of the antimicrobial effect of propolis with Chlorhexidine against oral pathogens: An in vitro study. Biomed Res Int 2016;2016:3627463. DOI: https://doi.org/10.1155/2016/3627463
34. Ferreira Bastos EM, Guzmán D, Figueroa J, Tello J, Scoaris DdO. Caracterización antimicrobiana y fisicoquímica de muestras de propóleos proveniente de Apis mellifera L. (Hymenoptera: Apidae) la Región Andina Colombiana. Acta Biol Colomb 2011;16(1):175-84.
35. Kujumgiev A, Tsvetkova I, Serkedjieva Y, Bankova V, Christov R, Popov S. Antibacterial, antifungal and antiviral activity of propolis of different geographic origin. J Ethnopharmacol 1999;64(3):235-40. DOI: https://doi.org/10.1016/s0378-8741(98)00131-7
36. Tovalino FRM, Contreras SS. Evaluación in vitro del efecto antibacteriano del extracto etanólico de propóleo de Oxapampa-Perú sobre cultivos de Streptococcus mutans (ATCC 25175) y Staphylococcus aureus (ATCC 25923). Rev Estomatol Hered 2010;20(1):19-24. DOI: https://doi.org/10.20453/reh.v20i1.1777
37. Gómez J, Peña N, Pérez C, Gutiérrez-Cortez C, Suarez Mahecha H. Evaluación por dos métodos in vitro de actividad antimicrobiana de propóleos frente a algunos microorganismos de interés alimentario. Rev Fac Nal Agr Medellín 2014;67 (Suppl 2):131-4. DOI: https://doi.org/10.13140/2.1.4919.3920
38. Cabrera-Rojas LAJ. Eficacia antimicrobiana in vitro del extracto etanólico de propóleo sobre cepas de Staphylococcus aureus [tesis licenciatura]. [Trujillo]: Universidad César Vallejos; 2016 [citado 26 de octubre de 2020]. Recuperado a partir de: https://repositorio.ucv.edu.pe/handle/20.500.12692/550
39. Bucio-Villalobos CM, Martínez-Jaime OA. Actividad antibacteriana de un extracto acuoso de propóleo del municipio de Irapuato, Guanajuato, México. Agron Mesoam 2017;28(1);223-7. DOI: https://doi.org/10.15517/am.v28i1.24253
40. Díaz-Mena D, Gil Rodríguez JD, Valdés González G. Determinación de la CMI de propóleos cubanos a partir de dos técnicas diferentes. Apiciencia 2000;2(2):1-12.
41. Mercan N, Kivrak I, Duru ME, Katircioglu H, Gulcan S, Malci S, et al. Chemical composition effects onto antimicrobial and antioxidant activities of propolis collected from different regions of Turkey. Ann Microbiol 2006;56(4):373-8. DOI: https://doi.org/10.1007/BF03175035
42. Gonsales GZ, Orsi RO, Fernandes Júnior A, Rodrigues P, Funari SRC. Antibacterial activity of propolis collected in different regions of Brazil. J Venom Anim Toxins Incl Trop Dis 2006;12(2): 276-84. DOI: https://doi.org/10.1590/S1678-91992006000200009
43. Moreno Z, Martínez P, Figueroa J. Efecto antimicrobiano in vitro de propóleos argentinos, colombianos y cubano sobre Streptococcus mutans ATCC 25175. Nova 2007;5(7):70-5. DOI: https://doi.org/10.22490/24629448.376
44. Gil M, Perelli A, Alvarado R, Arias Y, Blumenthal E. Actividad bacteriostática y bactericida de la tintura de propóleos sobre bacterias enteropatógenas. Salus 2012;16(3):21-5.
Notas
______
_______
Agradecemos también a las instituciones y editoriales que permiten que dichos trabajos puedan llegar a las manos de todos, y que además sean de utilidad para su uso práctico en pos de la salud.
_______
_______
_______
_______
_______
Notas de autor
Ken Jact Fernandez-León E-mail address: kenjactfl@gmail.com
Enlace alternativo